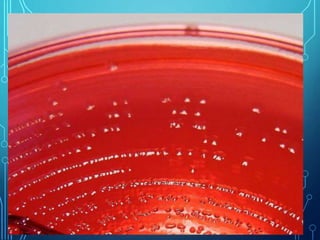
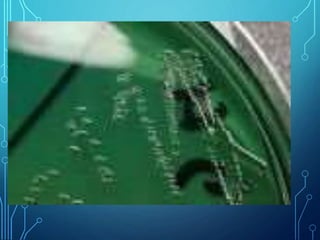
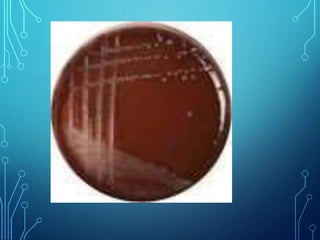

Shigella is a bacterium discovered over 100 years ago by a Japanese scientist. It causes shigellosis, which has led to epidemics with high death tolls. Shigella lives in the human intestines and is transmitted through the fecal-oral route. There are four subgroups of Shigella, with Shigella dysenteriae and flexneri causing the most severe illness. Symptoms include diarrhea with blood or mucus, abdominal pain, and fever. Treatment involves antibiotics, but many strains are becoming resistant. Prevention relies on handwashing, sanitation, water treatment, and reducing overcrowding.